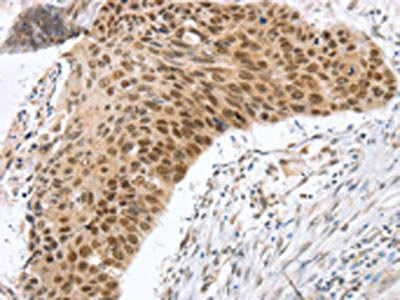

RNF20 Antibody
-
中文名稱:RNF20兔多克隆抗體
-
貨號:CSB-PA870281
-
規格:¥1100
-
圖片:
-
The image on the left is immunohistochemistry of paraffin-embedded Human esophagus cancer tissue using CSB-PA870281(RNF20 Antibody) at dilution 1/25, on the right is treated with fusion protein. (Original magnification: ×200)
-
Gel: 6%SDS-PAGE, Lysate: 40 μg, Lane 1-6: Lovo cells, A172 cells, A375 cells, 231 cells, Jurkat cells, hela cells, Primary antibody: CSB-PA870281(RNF20 Antibody) at dilution 1/350, Secondary antibody: Goat anti rabbit IgG at 1/8000 dilution, Exposure time: 5 seconds
-
-
其他:
產品詳情
-
Uniprot No.:
-
基因名:RNF20
-
別名:BRE1 A antibody; BRE1 antibody; BRE1 E3 ubiquitin ligase homolog antibody; BRE1-A antibody; BRE1A antibody; BRE1A_HUMAN antibody; E3 ubiquitin-protein ligase BRE1A antibody; hBRE1 antibody; Homolog of S. cerevisiae BRE1 antibody; RING finger protein 20 antibody; Ring finger protein 20 E3 ubiquitin protein ligase antibody; Rnf20 antibody
-
宿主:Rabbit
-
反應種屬:Human,Mouse
-
免疫原:Fusion protein of Human RNF20
-
免疫原種屬:Homo sapiens (Human)
-
標記方式:Non-conjugated
-
抗體亞型:IgG
-
純化方式:Antigen affinity purification
-
濃度:It differs from different batches. Please contact us to confirm it.
-
保存緩沖液:-20°C, pH7.4 PBS, 0.05% NaN3, 40% Glycerol
-
產品提供形式:Liquid
-
應用范圍:ELISA,WB,IHC
-
推薦稀釋比:
Application Recommended Dilution ELISA 1:2000-1:10000 WB 1:1000-1:5000 IHC 1:20-1:100 -
Protocols:
-
儲存條件:Upon receipt, store at -20°C or -80°C. Avoid repeated freeze.
-
貨期:Basically, we can dispatch the products out in 1-3 working days after receiving your orders. Delivery time maybe differs from different purchasing way or location, please kindly consult your local distributors for specific delivery time.
-
用途:For Research Use Only. Not for use in diagnostic or therapeutic procedures.
相關產品
靶點詳情
-
功能:Component of the RNF20/40 E3 ubiquitin-protein ligase complex that mediates monoubiquitination of 'Lys-120' of histone H2B (H2BK120ub1). H2BK120ub1 gives a specific tag for epigenetic transcriptional activation and is also prerequisite for histone H3 'Lys-4' and 'Lys-79' methylation (H3K4me and H3K79me, respectively). It thereby plays a central role inb histone code and gene regulation. The RNF20/40 complex forms a H2B ubiquitin ligase complex in cooperation with the E2 enzyme UBE2A or UBE2B; reports about the cooperation with UBE2E1/UBCH are contradictory. Required for transcriptional activation of Hox genes. Recruited to the MDM2 promoter, probably by being recruited by p53/TP53, and thereby acts as a transcriptional coactivator. Mediates the polyubiquitination of isoform 2 of PA2G4 in cancer cells leading to its proteasome-mediated degradation.
-
基因功能參考文獻:
- the RNF20/40 complex, a major ubiquitin ligase catalysing histone H2B monoubiquitination, interacts with the motor protein Eg5 during mitosis and participates in spindle assembly. PMID: 27557628
- data indicate that RNF20 and PARP1 are synthetic lethal interactors PMID: 28462496
- RNF20 depletion stabilizes the ZSCAN4 protein half-life, suggesting that RNF20 negatively regulates ZSCAN4 stability. PMID: 29477841
- The effects of RNF20 on mammary tumorigenesis are subtype dependent: In basal-like cancers cells, RNF20 suppresses the NF-kappaB-dependent expression of cytokines, known to contribute to the growth of this tumor subtype. PMID: 28157208
- The authors also show that the RING domains of RNF20 and RNF40 can form a stable heterodimer that is active. PMID: 27569044
- Manipulation of key H2Bub1 E3 ubiquitin ligases, RNF20, RNF40 and BRCA1, in ovarian cancer cell line models modulated H2Bub1 levels, indicative of the role of these RING finger ligases in monoubiquitination of H2Bub1 in vitro PMID: 27798111
- RNF20 and H2Bub1 promotes chronic colonic inflammation and inflammation-associated colorectal cancer in mice and humans, partly by augmenting NF-kappaB activity and attenuating the antitumoral T cell response. PMID: 26854224
- It was observed that RE-IIBP induces MEIS1-mediated apoptosis, which was dependent on H2BK120 ubiquitination by RNF20. PMID: 26206755
- A primary role for FACT in RNF20 recruitment chromatin remodeling for initiation of homologous recombination repair. PMID: 24357716
- The ability of E1A to target hBre1 to simultaneously repress cellular IFN dependent transcription while activating viral transcription PMID: 23785282
- model whereby cotranscriptional recruitment of Rnf20 at MLL-fusion target genes leads to amplification of Dot1l-mediated H3K79 methylation, thereby rendering leukemia cells dependent on Rnf20 to maintain their oncogenic transcriptional program PMID: 23412334
- We show that Bre1 (human BRE1A/B (RNF20/40) and mouse Bre1a/b (Rnf20/40)) acts as an important suppressor of chromosomal instability PMID: 22354749
- our results suggest that RNF20 and RNF40, either via ubiquitylation of H2B or other targets, are coupled to the proliferation of prostate cancer cells. PMID: 22155569
- Studies indicate that H2B monoubiquitylation is driven primarily by an E3 ubiquitin ligase composed of the two RING finger proteins RNF20 and RNF40. PMID: 21827756
- RNF20, presumably via H2Bub, selectively represses oncogenic genes by interfering with chromatin recruitment of TFIIS, a factor capable of relieving stalled RNA polymerase II. RNF20 inhibits the interaction between TFIIS and the PAF1 complex. PMID: 21596312
- RNF20-mediated H2B ubiquitination at DSBs plays a critical role in HRR through chromatin remodeling PMID: 21362548
- the observed defects in the radiation response of Bre1a/b-deficient cells PMID: 20738173
- RNF20 overexpression leads to elevated histone 2B monoubiquitination, subsequently higher levels of methylation at H3 lysines 4 and 79, and stimulation of homeobox gene expression. PMID: 16307923
- The Bre1 protein specifically increases the global level of H2B ubiquitylation at lysine 120 and enhances activator-dependent transcription. PMID: 16337599
- identified as one of five genes containing 11 somatic mutations in a panel that included 132 colorectal cancers, then demonstrated that down-regulation of such homologs resulted in chromosomal instability and chromatid cohesion defects in human cells PMID: 18299561
- RNF20 suppresses the expression of several proto-oncogenes, which reside preferentially in closed chromatin and are modestly transcribed despite bearing marks usually associated with high transcription rates. PMID: 18832071
- hBre1 inhibits Ebp1's tumor suppressive activity through mediating its polyubiquitination and degradation. PMID: 19037095
- In humans, the 600 kDa RNF20/40 complex is the E3 ligase. PMID: 16307923
- Functional analysis of the yeast counterpart PMID: 12535538
顯示更多
收起更多
-
亞細胞定位:Nucleus.
-
蛋白家族:BRE1 family
-
組織特異性:Expressed in the normal brain and also in malignant gliomas (at protein level).
-
數據庫鏈接:
Most popular with customers
-
-
YWHAB Recombinant Monoclonal Antibody
Applications: ELISA, WB, IHC, IF, FC
Species Reactivity: Human, Mouse, Rat
-
Phospho-YAP1 (S127) Recombinant Monoclonal Antibody
Applications: ELISA, WB, IHC
Species Reactivity: Human
-
-
-
-
-